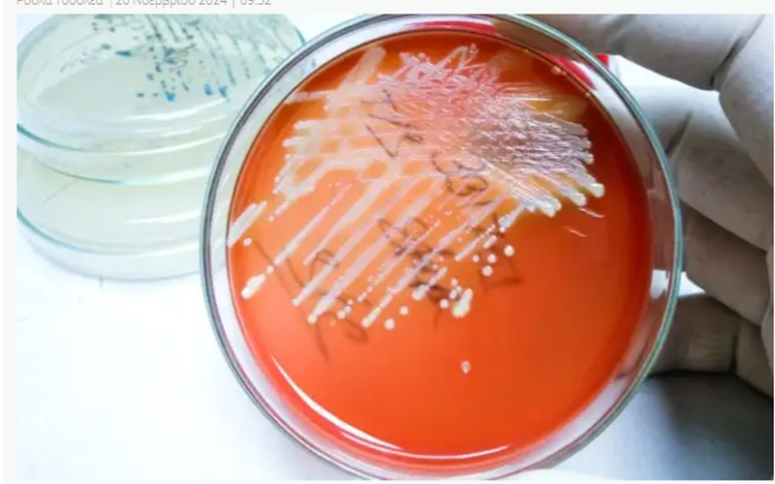

Χρυσίζων σταφυλόκοκκος: Τι πρέπει να γνωρίζουμε για το επικίνδυνο βακτήριο
Θλίψη προκάλεσε η είδηση ότι ο γνωστός ψυχίατρος Δημήτρης Σούρας έχασε τη ζωή του από βαριά σηψαιμία που του προκάλεσε απόστημα μολυσμένο με το βακτήριο χρυσίζων σταφυλόκοκκος. Πώς μπορεί μία μόλυνση στο δέρμα να έχει αυτή την κατάληξη; Ο χρυσίζων σταφυλόκοκκος είναι ένα από τα 45 βακτήρια του γένους του σταφυλοκόκκου. Υπάρχει στο δέρμα και…